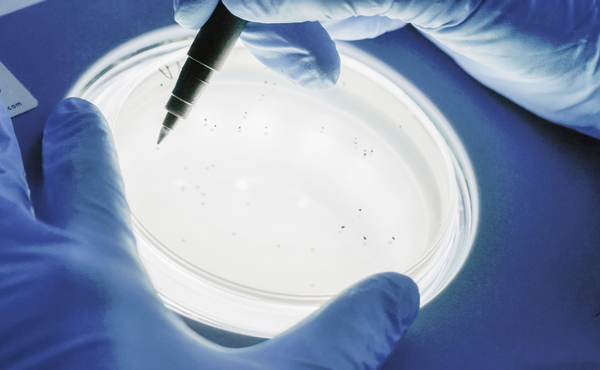
Sterilisationsprüfung im Labor von HA2 in Sachsen-Anhalt

Laden Sie sich hier das Zertifikat herunter:
Zertifizierungen
Die Sterilisation von Medizinprodukten und pharmazeutischen Produkten erfordert höchste Anforderungen an Prozesssicherheit, Nachvollziehbarkeit und regulatorische Konformität. Unser Qualitätsmanagementsystem stellt sicher, dass alle Prozesse klar definiert, dokumentiert und kontinuierlich überwacht werden.
Regelmäßige interne und externe Audits gewährleisten die Einhaltung der geltenden Normen und unterstützen eine stetige Verbesserung unserer Abläufe.